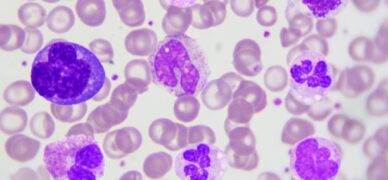
Bazofil düşüklüğü

Başlıklar
Bazofil nedir?
Alerjik reaksiyonlarda etkin rol oynayan bazofiller; lökositlerin (beyaz kan hücrelerinin/akyuvarların) alt tiplerinden birisi olup, sayısı en az olan lökosit türüdür. Bazofillerin kanda fazla görülmesi gerçekten ciddi bir durumun işaretidir ve altında yatan sebep derhal öğrenilmezse ölümcül olabilir.
Normalde bazofillerin 1 mikrolitre kanda 200’den az bulunması gerekir. 2000’in üzerindeki bazofil oranı tehlikelidir. Çünkü bazofiller yüksek oranda histamin isimli bileşeni barındırır. Bu bileşen, dokulara kanın daha hızlı akmasını sağlayan bir bileşendir.
Kan dokulara hızlı aktığında, bazofiller zararlı partiküllere çok daha hızlı müdahale edebilir. Genellikle alerjik reaksiyon durumlarında ortaya çıkar. Vücudun içine alerji ya da enfeksiyon yapacak bir canlı (bakteri, virüs, parazit) ya da cisim girdiğinde bazofiller hemen o bölgeye giderek o canlının ya da maddenin civarında iltihap oluşturur. Amaç vücut dokularını o maddeden korumak ve ondan kurtulmaktır.
Bazofiller lökositlerin (beyaz kan hücrelerinin) yaklaşık %1’ini oluşturur ve kemik iliğinden üretilirler. Vücudun savunma mekanizmasının en önemli parçalarından birisidir. Kısaca BAS şeklinde ifade edilir ve laboratuar sonuçlarında da bu ifade kullanılır. Her laboratuarda Bazofil değer aralığı birbirinden farklı olabilir. Bu fark, kullanılan ölçüm biriminden kaynaklıdır. Aynı ölçüm birimi kullanıldığı halde normal değer aralıkları çok küçük bir miktar oynayabilir.
Bazofil yüksekliği ya da bazofil düşüklüğü yapan durumlar sadece alerjik durumlar değildir. Kemik iliğinde çıkan bazı sorunlar sebebiyle bazofil hücresi gereğinden fazla ya da gereğinden az üretiliyor olabilir. Örneğin lösemi hastalığı BAS yüksekliği ya da BAS düşüklüğü oluşturan sebeplerin başında gelir. Bu ve bunun gibi pek çok iltihaplı hastalık, enfeksiyon ve kanser çeşitleri BAS oranında ciddi oynamalara sebep olmaktadır.
- Bir önceki yazımızda Lenfosit düşüklüğü ve Lenfosit yüksekliği konusunu ele almıştık. Okumak için Lenfosit düşüklüğü ve Lenfosit yüksekliği yazısını okuyabilirsiniz.
- Bir sonraki yazımızda ise, Bazofil düşüklüğü konusundan bahsettik. Okumak için Bazofil düşüklüğü yazısını okuyabilirsiniz.

1 Yorum
Bazofil düşüklüğü nedir? | Bazofil düşüklüğü sebebi olan durumlar
[…] önceki yazımızda Bazofil konusunu ele almıştık. Okumak için Bazofil yazısını […]
4 Aralık 2023 - 22:44